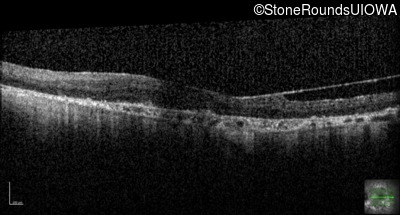

SR96
Type 1 Usher Syndrome (IB1a)
Male
Male
SR96
Student Mode
1Type 1 Usher Syndrome (IB1a)
2Male
Male
History
This 62 year old man has had profound hearing loss since birth and has communicated using sign language for his entire life. He first noticed a problem with his vision at about age 11 when he noticed night blindness and began to trip over objects that he should have seen.
| Age at visit: 62 years |
| Age at visit: 64 years (Visit 2) |
| OD | OS | ||
|---|---|---|---|
| OD | OS | ||
|---|---|---|---|
| Age at visit: 67 years |
| OD | OS | ||
|---|---|---|---|
| Age at visit: 71 years |
| OD | OS | ||
|---|---|---|---|
Diagnosis & molecular findings
| Disease | Gene | Allele 1 variant(s) | Allele 2 variant(s) | Inheritance mode |
|---|---|---|---|---|
| Type 1 Usher Syndrome | USH1C | Thr78 ins1aC | Thr78 ins1aC | AR |
Disease:
Gene:
Allele 1:
Thr78 ins1aC
Allele 2:
Thr78 ins1aC
Inheritance:
AR